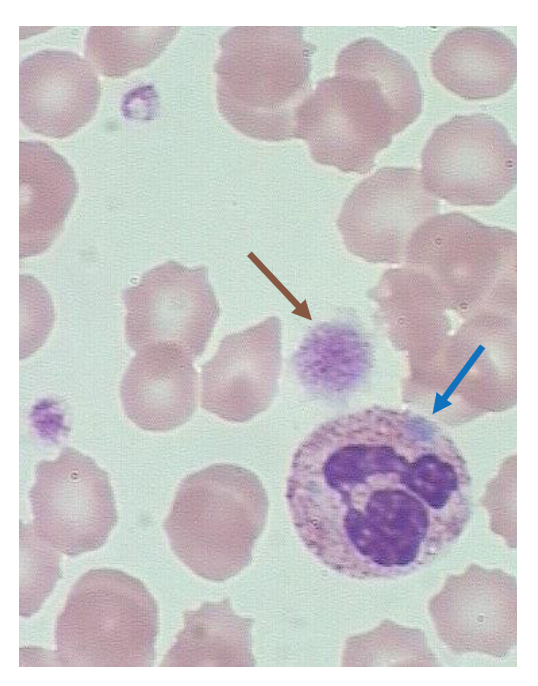
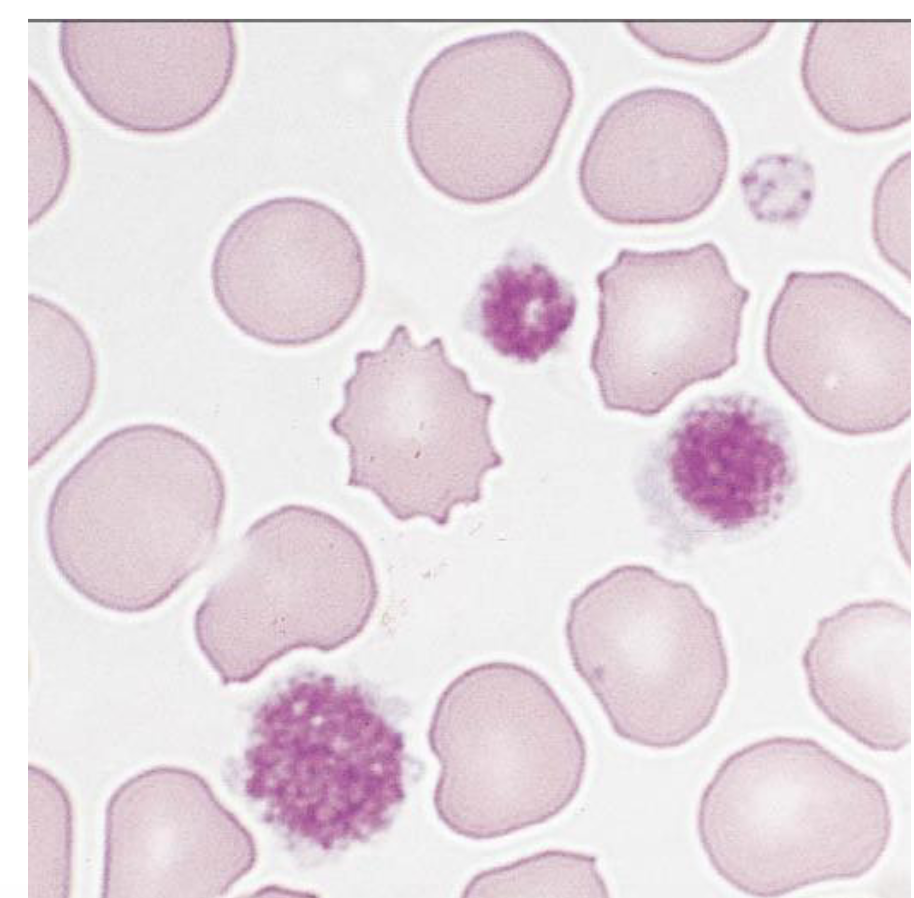
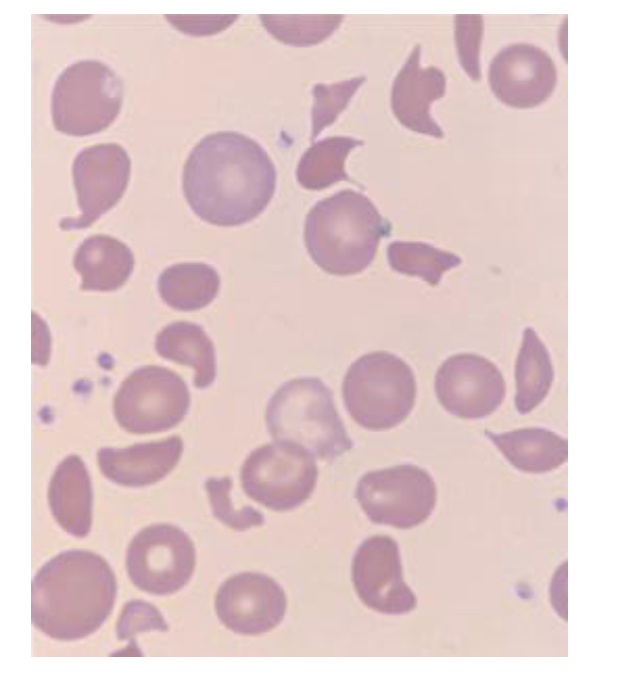

What platelet abnormality is often seen in individuals who have been on a by-pass machine?
platelets get degranulated by the by-pass machine- so may have an acquired platelet dysfunction when they come out of surgery
What is the platelet function in primary hemostasis?
- vessel injury
- exposure of collage & vWF
- platelet adhesion
- platelet activation
- platelet aggregation
- primary hemostatic plug
- stabilized by fibrin meshwork
What clinical findings are seen in platelet dysfunction or thrombocytopenia?
- petechiae
- ecchymoses
- epistaxis
- menorrhagia
- GI hemorrhage
- Gingival bleeding
- Post-partum hemorrhage
- post-operative bleeding
Identify the different types of bruising seen in the provided image. These symptoms are seen in what conditions?

platelet dysfunction or thrombocytopenia

What are the type of thrombocytopenia?
- decreased production
- decreased survival
- sequestration
- dilution
What are the types of thrombocytosis?
- reactive
- infectious/trauma
- iron deficiency
- carcinoma
- exercise
- neoplastic
- myeloproliferative
What are the causes of defective platelet function & associated conditions?
- defective adhesion (Benard-Soulier)
- defective aggregation (Glanzmann thrombasthenia)
- defective secretion (storage pool disorder)
- liver disease
- uremia
- drug
What is Mey-Hegglin Anomaly?
Inheritance pattern?
Peripheral blood smear?
hereditary thrombocytopenia disorder
autosomal dominant
normal platelet function & not associated with bleeding
- mild thrombocytopenia
- large platelets
- Dohle-like bodies in leukocytes
What mutation is seen in Benard-Soulier syndrome?
mutation in GPIb, which causes a decreased membrane GPIb-V-IX (receptor for vWF & is necessary for platelet adhesion)
Bernard-Soulier syndrome causes what type of platelet dysfunction?
inheritance pattern?
Peripheral blood smear?
defective adhesion after injury -moderate to severe bleeding
autosomal recessive
- platelets are large (like May-Hegglin, but these have impaired function)
The provided smear could be from what two conditions? How could you tell them apart?

large platelets
May-Hegglin Anomaly (platelets are functional)
Benard-Soulier syndrome (impaired adhesion)
What mutation is seen in Glanzmann Thrombasthenia?
deficiency or dysfunction in GPIIb/IIIa, a protein that binds to fibrinogen & vWF during platelet adhesion & aggregation
Glanzmann Thrombasthenia causes what type of platelet dysfunction?
inheritance pattern?
Peripheral blood smear?
defective platelet aggregation in homozygotes (heterozygotes are asymptomatic)
autosomal recessive
- normal platelet count & morphology but abnormal function
What CBC values do you see in a patient with Primary Immune Thrombocytopenic purpura (ITP)?
- severe (<20K) thrombocytopenia
- often large, immature platelets
- all other counts are normal

What is the clinical presentation of a patient with chronic Primary Immune Thrombocytopenic purpura?
Treatment?
- Female 20-40yr
- insidious onset
- mucocutaneous bleeding
- NO systemic symptoms
- NO splenomegaly
- Treatment
- corticosteroids, IVIg & sometimes splenectomy
What is the cause of chronic Primary Immune Thrombocytopenia (ITP)?
autoantibodies against platelet antigen → peripheral destruction
Why is it not helpful to test for anti-platelet antibodies in the diagnosis of ITP?
it is not sensitive nor specific
negative result does not rule out ITP
What is the cause of acute ITP?
IgG antibodies directed against GP IIb-IIIa on platelets
What is the clinical presentation of a patient with acute ITP?
usually young child
abrupt onset - triggered by viral infection (1-3 weeks prior)
Secondary ITP is associated with what conditions?
autoimmune diseases, lymphomas, viral infections (HIV, HepC) & drugs (quinidine, heparin)
What is the definition of RBC fragmentation syndrome with thormbocytopenia?
non-immune hemolytic anemia resulting from intravascular RBC fragmentation, usually within small arterioles & capillaries - possibly from artificial heart valves or ventricular assist devices

What is disseminated intravascular coagulation?
formation widespread microvascular thrombi after activationof coagulation cascade by tissue factor or mimic, resulting in microangiopathic hemolytic anemia & thrombocytopenia
body degrades newly formed fibrin → consumptive coagulopathy & bleeding diathesis

What laboratory values will you see in patient with DIC?
PT, PTT, & TT may be prolonged (sometimes normal in early stages)
low fibrinogen
elevated D-dimer
elevated FDP
What peripheral blood findings are consistent with DIC?
schistocytes